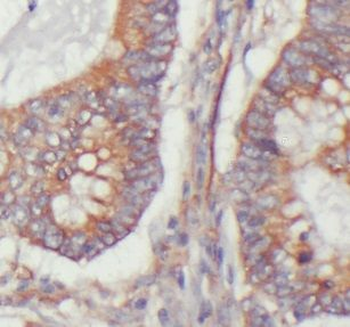
USP11 Rabbit Polyclonal Antibody

You have no items in your shopping cart.
USP11 Antibody
SKU: orb672396
Description
Research Area
Epigenetics & Chromatin
Images & Validation
−Item 1 of 1
| Tested Applications | ELISA, WB |
|---|---|
| Dilution Range | WB: 1:500-1:2000, ELISA: 1:20000 |
| Reactivity | Human, Mouse, Rat |
Key Properties
−| Host | Rabbit |
|---|---|
| Clonality | Polyclonal |
| Isotype | IgG |
| Immunogen | Synthesized peptide derived from the Internal region of Human USP11. |
| Target | USP11 |
| Purification | The antibody was affinity-purified from rabbit antiserum by affinity-chromatography using epitope-specific immunogen. |
| Conjugation | Unconjugated |
Storage & Handling
−| Storage | Maintain refrigerated at 2-8°C for up to 2 weeks. For long term storage store at -20°C in small aliquots to prevent freeze-thaw cycles. |
|---|---|
| Form/Appearance | Liquid |
| Buffer/Preservatives | Liquid in PBS containing 50% glycerol, 0.5% rAlbumin and 0.02% sodium azide. |
| Expiration Date | 12 months from date of receipt. |
| Disclaimer | For research use only |
Alternative Names
−Anti-USP11 antibody, anti-UHX1 antibody, anti-Ubiquitin carboxyl-terminal hydrolase 11 antibody, anti-Deubiquitinating enzyme 11 antibody, anti-Ubiquitin thioesterase 11 antibody, anti-Ubiquitin-specific-processing protease 11 antibody
Similar Products
−USP11 rabbit pAb Antibody [orb767276]
ELISA, IF, WB
Human, Mouse, Rat
Polyclonal
Unconjugated
100 μl, 50 μlUSP11 Rabbit Polyclonal Antibody [orb632425]
ELISA, IHC, IP, WB
Human
Rabbit
Polyclonal
Unconjugated
100 μg, 50 μgUSP11 Rabbit Polyclonal Antibody [orb632424]
ELISA, IF, IHC, IP, WB
Human
Rabbit
Polyclonal
Unconjugated
50 μg, 100 μg

Quality Guarantee
Explore bioreagents carefree to elevate your research. All our products are rigorously tested for performance. If a product does not perform as described on its datasheet, our scientific support team will provide expert troubleshooting, a prompt replacement, or a refund. For full details, please see our Terms & Conditions and Buying Guide. Contact us at support@biorbyt.com.

Western blot analysis of 293 cells using USP11 antibody
Quick Database Links
Gene Symbol
USP11
UniProt
UniProt Details
− No UniProt data available
Documents Download
Datasheet
Product Information
Request a Document
Protocol Information
WB
Western Blot (IB, immunoblot)
ELISA
Enzyme-linked Immunosorbent Assay (EIA)
USP11 Antibody (orb672396)
Based on 0 reviews
Participating in our Biorbyt product reviews program enables you to support fellow scientists by sharing your firsthand experience with our products.
Login to Submit a Review